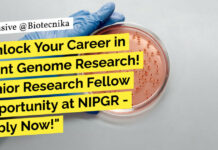
NIPGR Molecular Biology JRF Job - Life Sciences, Biotech & Biochem Apply

Home 2024
Yearly Archives: 2024
Novartis Data Science Expert Role For Computational Biology, Apply Online
Novartis Data Science Expert Role For Computational Biology, Apply Online
Expert Data Science
Job ID REQ-10012872
Sep 02, 2024
India
Summary
Artificial Intelligence and Computational Sciences: Biomedical Research.
The AI &...
Top 10 Essential Bioinformatics Tools & Techniques For Successful Biotech Experiments
Top 10 Bioinformatics Tools & Software
Biotechnology is an evolving field that relies heavily on various emerging tools, techniques, and technologies. Proficiency in these tools...
NCBS Scientific Officer Vacancy With Rs. 67,700 pm Pay For Biotech & Life Sciences...
NCBS Scientific Officer Vacancy With Rs. 67,700 pm Pay For Biotech & Life Sciences - Apply Online
NCBS Scientific Officer Vacancy With Rs. 67,700 pm...
Biotecnika Times Newsletter 03.09.2024 – Freshers Jobs, 2025 NIAB 6 Month Training Programme, Biocon...
Freshers Jobs! SJRI Research Assistant Position For Biotech & Biochem - Apply Online
St. John's Research Institute is offering opportunities for freshers in MSc Biotechnology...
Field Application Specialist Opportunity at Sartorius – Apply Online
Field Application Specialist Opportunity at Sartorius - Apply Online
Field Application Specialist Separation Technology (Pune)
Locations: Mumbai
Time type: Full time
Posted on: Posted Today
Job Requisition ID: R33060
...
Exciting Opportunity at ThermoFisher Scientific Inc. – Scientist II Position Now Open!
ThermoFisher Scientific Inc Job - Mol Bio & Life Sciences Apply
Scientist II, Protein Biology
Location: Bangalore, Karnataka, India
Job Id: R-01267698
Job Type: Full time
Category: Research &...
Freshers Jobs! SJRI Research Assistant Position For Biotech & Biochem – Apply Online
Freshers Vacancies at SJRI - MSc Biotech & Biochem Apply Online
Research Assistant - Analytical Project
Division: Non Division User
Project / Title: Analytical Project
Contact Person: Mrs....
Pfizer Biotechnology Associate Role – BSc & MSc Apply Online
Pfizer Biotechnology Associate Role - BSc & MSc Apply Online
Senior Associate I - Regulatory Change Manager
Locations: India - Chennai
Time type: Full time
Posted on: Posted...
2025 NIAB 6 Month Training Programme / Dissertation Work Call For Applications
NIAB Dissertation Training 2025 - Dissertation Work For Life Sciences
NIAB Dissertation Training 2025 - Dissertation Work For Life Sciences. Six-month programme at NIAB. Applications...
Junior Research Fellow Opportunity at NIPGR – Apply Now!
NIPGR Molecular Biology JRF Job - Life Sciences, Biotech & Biochem Apply
Date: September 02, 2024
Applications are invited from suitable candidates for filling up purely...
Biocon Biologics Life Sciences R&D Job Opportunity – Apply Now
Biocon Biologics Life Sciences R&D Job Opportunity - Apply Now
Biocon Biologics
Research & Development: Opportunities in Characterization Development Lab
About the job
Biocon Biologics is a fully-integrated...
IFF Biotech, Biochem & Food Tech Application Technologist Job – Apply Online
IFF Application Technologist Job Opening - Biotech, Biochem & Food Tech Apply
Application Technologist
Remote type: On-site
Locations:
Hyderabad IAC, India
Chennai (Guindy), India
Mumbai, India
Gurugram, India
Bengaluru, India
Time type: Full...
Kickstart Your Bioinformatics Career: Download Free Bioinformatics Market Research Report PDF
Kickstart Your Bioinformatics Career: Download Free Bioinformatics Market Research Report PDF
Are you a young researcher or recent graduate eager to make your mark in...
Exciting Microbiology QC Analyst Job Opportunity at Endo – Apply Now
Microbiology QC Analyst Job Opportunity at Endo - Apply Now
Analyst, QC Microbiology
Locations: India - Indore
Time type: Full time
Posted on: Posted Today
Job Requisition ID: R001674
Job...
Biocon KGI Certificate Program in Biosciences Batch 28 | Admissions Open
Biocon Batch 28 KGI Certificate Program in Biosciences Admissions Open
Biocon KGI Certificate Program in Biosciences
Biocon Academy's flagship program, the Biocon KGI Certificate Program in...